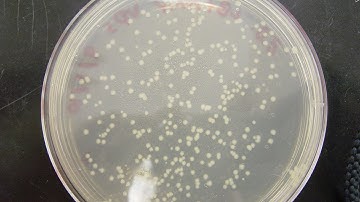
CFU: Colony Forming Unit & cfu/ml calculation

⬇ DOWNLOAD NOW
Jika muncul iklan pop-up, tutup lalu klik tombol kembali
Download lagu Calculate Colony Forming Units | Microbiolgy CFU/ml Count secara gratis hanya untuk keperluan promosi. Dukung artis favorit kamu dengan membeli musik original di iTunes atau platform resmi lainnya.
 How to Calculate CFU per ml of Bacterial Sample? in 3 Steps || cfu/ml in Microbiology
How to Calculate CFU per ml of Bacterial Sample? in 3 Steps || cfu/ml in Microbiology How to calculate colony forming units (cfu/mL) in excel
How to calculate colony forming units (cfu/mL) in excel From One Cell to Billions - Colony Forming Units
From One Cell to Billions - Colony Forming Units Colony Forming Units (CFUs) in Microbiology: Estimating Bacterial Concentrations | Microbiology Lab
Colony Forming Units (CFUs) in Microbiology: Estimating Bacterial Concentrations | Microbiology Lab CFU | How to Calculate Colony Forming Units (CFU/ml) | Microbiology @biotechnotebook
CFU | How to Calculate Colony Forming Units (CFU/ml) | Microbiology @biotechnotebook CFU: Colony Forming Unit & cfu/ml calculation
CFU: Colony Forming Unit & cfu/ml calculation Instructional Video - Counting Colonies
Instructional Video - Counting Colonies Total Plate Count (Total Aerobic Bacterial Count)_A Complete Procedure (BAM, Ch-3)
Total Plate Count (Total Aerobic Bacterial Count)_A Complete Procedure (BAM, Ch-3)